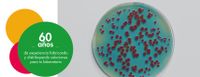
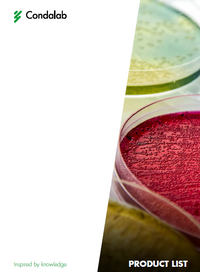

CATÁLOGOS Y PROMOCIONES
Aquí también podrá encontrar las ofertas más recientes de nuestros principales proveedores.
Enzimas de restricción
Agarosas
- Agar Bacteriológico Americano
- Agar Bacteriológico Europeo
- Agar Farmaceútico
- Agar Industrial
- Agar para Propagación de Platas (PPA)
- Agar purificado
¡NUEVO!
Descubre cómo MagBio puede optimizar tu trabajo de laboratorio. Contáctanos para más detalles. (Oferta válida hasta el 18 de diciembre)
TOP 10 POLIMERASAS DE CONDALAB
En Disbiotec, nos enorgullece ofrecerte una selección de las 10 mejores taq polimerasas del mercado gracias a nuestro proveedor Condalab. Nuestra experiencia y dedicación en el campo de la biotecnología nos permiten garantizar la calidad y el rendimiento de cada producto que ofrecemos.
*Oferta válida hasta el 31 de diciembre de 2014
Pinche sobre la imágen para descargar la oferta
OLIGOS DNA EN TUBO | SONDAS DNA DUAL LEBELLED |
|
Otros servicios:
Premixes de 5 y de 25 ml. Pinche en la imágen para descargar la oferta.
FLYERS CONDALAB:
¡NOVEDAD! Condalab lanza su propio equipo de Real Time PCR.
*Solicitar oferta
CATÁLOGOS MARCAS ECOGEN:
CATÁLOGO BIOLINE: Biología molecular y fungibles. | CATÁOLOGO STARLAB: Fungibles. |
|
FLYERS DE ZYMO:
Biotecnología, epigenética, microbiómica y secuenciación. Aquí les mostramos los flyers de Zymo, marca con la que trabajamos a traves de nuestro proveedor Ecogen.
* Pueden solicitar su muestra gratuita a través de la web: https://www.zymoresearch.com/
CATÁLOGOS GENERALES: |
¡Aproveche la promoción de ESENCIALES-2024 de nuestro proveedor AUXILAB! les presentamos descuentos exclusivos en productos indispensables para su laboratorio.
*Haga clic sobre la imagen para descargar el catálogo
CATÁLOGO COBOS: Balanzas. | ¡NUEVO! CATÁLOGO LABBOX 2024: Ciencias de la vida, cromatografía, refractomeros, agitadores, termostización, combustión, calcinización. | |
CATÁLOGO LABPROCESS: Instrumentos de electroquímica y analítica de procesos. | CATÁOLOGO INDELAB: Fabricantes de mobiliario y equipos para laboratorio general. | |

.png/picture-200?_=1896b5a9e9d)